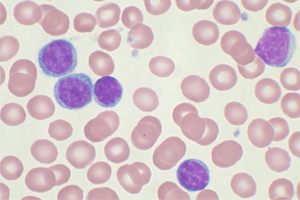

Норма эозинофилов в крови 1-5
Нормальный уровень эозинофилов в крови составляет от 1 до 5% от общего числа лейкоцитов. Эта норма одинакова для мужчин и женщин. Для определения количества эозинофилов используется метод лазерной проточной цитометрии.
Эозинофилы также можно измерять в абсолютных значениях. В этом случае нормальные показатели колеблются от 120 до 350 эозинофилов на миллилитр крови.
На уровень эозинофилов в крови значительно влияют надпочечники. Если кровь берется в первой половине ночи, содержание эозинофилов может быть на 30% выше. Утром этот показатель увеличивается на 15%.
Для получения наиболее точных результатов рекомендуется:
- Сдавать кровь в утренние часы и натощак.
- За несколько дней до анализа исключить сладкие продукты и алкоголь.
- Учитывать, что менструальный цикл женщины также влияет на уровень эозинофилов. Во время овуляции их количество снижается и остается таким до конца цикла. Врачи разработали эозинофильный тест, который помогает определить пик созревания яйцеклетки. Чем выше уровень прогестерона в крови, тем ниже количество эозинофилов, в то время как эстроген способствует увеличению этого показателя.
Повышенный уровень эозинофилов в крови может свидетельствовать о различных состояниях, включая аллергические реакции, инфекции или заболевания, связанные с воспалением. Врачи рекомендуют в первую очередь обратиться к специалисту для определения причины повышения. Нормальные значения эозинофилов варьируются, но обычно составляют от 0 до 0,5 х 10^9 клеток на литр крови. При выявлении повышенных показателей важно провести дополнительные исследования, такие как анализы на аллергены или паразитов. В зависимости от результатов, врач может назначить лечение, которое может включать антигистаминные препараты, кортикостероиды или другие медикаменты. Самолечение в данном случае не рекомендуется, так как это может усугубить состояние.

Норма показателей эозинофилов для детей
Содержание эозинофилов в крови у детей изменяется незначительно по мере их роста.
| Возраст ребёнка | Процентное содержание эозинофилов |
| ≥ 14 дней | 1-6% |
| 15 дней – 12 месяцев | 1-5% |
| 1,5-2 года | 1-7% |
| От 2 до 5 лет | 1-6% |
| ≤ 5 лет | 1-5% |
Что означает увеличение нормы эозинофилов?
Если в 1 мл крови обнаруживается более 700 эозинофилов (7×10^9 г/л), это значительное отклонение от нормы. В медицинской практике такое состояние называется эозинофилией.
- Легкая степень эозинофилии — увеличение количества эозинофилов на 10%.
- Умеренная эозинофилия — рост эозинофилов на 10-15%.
- Тяжелая эозинофилия — увеличение уровня эозинофилов на 15% и более. При таких значениях ткани и органы могут испытывать недостаток кислорода, что негативно сказывается на их функционировании.
При анализе возможны погрешности, так как эозинофилы окрашиваются красителем эозином, что может привести к ошибкам. Поэтому, если результаты показывают уровень нейтрофилов ниже нормы и эозинофилов выше, рекомендуется повторный забор крови.
Эозинофилы — это тип белых кровяных клеток, которые играют важную роль в иммунной системе, особенно в борьбе с аллергиями и паразитами. Повышенный уровень эозинофилов в крови, известный как эозинофилия, может вызывать беспокойство. Люди часто задаются вопросом, что это может означать и какие меры предпринять. Нормальный уровень эозинофилов варьируется от 0 до 0,5 × 10^9 клеток на литр крови. Если анализ показывает превышение этой нормы, это может указывать на различные состояния, такие как аллергические реакции, инфекции, аутоиммунные заболевания или даже некоторые виды рака. Важно не паниковать, а обратиться к врачу для дальнейшего обследования. Специалист может назначить дополнительные анализы и, в зависимости от причины повышения, предложить соответствующее лечение или рекомендации по изменению образа жизни.

Причины эозинофилии
Повышенное содержание эозинофилов в крови указывает на аллергическую нагрузку на организм. Это может быть вызвано различными состояниями, такими как:
- Аллергия на медикаменты.
- Аллергические реакции немедленного типа (например, сенная лихорадка, отёк Квинке, крапивница).
- Аллергический ринит.
- Кожные аллергические проявления (экзема, контактный и атопический дерматит, пузырчатка).
- Паразитарные инфекции (инвазии амебами, хламидиями, токсоплазмами).
- Глистные инвазии.
- Системные заболевания (красная волчанка, ревматоидный артрит, фасциит, узелковый периартериит).
- Острые и хронические инфекционные болезни (сифилис, вирус Эпштейна-Барра, туберкулёз).
- Заболевания органов дыхания (астма, саркоидоз, плеврит эозинофильной природы, фиброзирующий альвеолит, болезнь Лефлера, гистоцитоз).
- Онкологические заболевания крови (лимфома, лимфогранулёматоз).
- Заболевания пищеварительной системы (гастрит и колит эозинофильной природы).
- Злокачественные опухоли.
При выявлении эозинофилии у взрослого пациента назначают следующие анализы:
- Анализ кала на яйца глистов.
- Биохимический анализ крови.
- Ультразвуковое исследование органов брюшной полости.
Пациенту также необходимо посетить аллерголога. В зависимости от ситуации врач может назначить:
- Мазок из зева и носовых проходов для определения уровня эозинофилов при аллергическом рините.
- Провокационные тесты и спирометрию при подозрении на астму.
- Определение аллергенов по сыворотке крови.
В дальнейшем пациент получает рекомендации от врача и проходит лечение соответствующего заболевания. Если у пациента есть проблемы с лёгкими, его направляют к пульмонологу. В случае паразитарных инфекций необходимо обратиться к инфекционисту.
Причины повышения уровня эозинофилов у детей
| Новорождённые и дети до шести месяцев | От 6 месяцев до 3 лет | До 3 лет |
| * Гемолитическая болезнь новорождённых; * Иммунологическая несовместимость по резус-фактору с матерью; * Пемфигус; * Стафилококковая инфекция (сепсис или энтероколит); * Эозинофильный колит; * Сывороточная болезнь. | * Аллергия на медикаменты; * Отёк Квинке; * Атопический дерматит. | * Инфекция гельминтами; * Аллергический ринит; * Кожные аллергические реакции; * Скарлатина; * Онкологические заболевания крови; * Бронхиальная астма; * Ветряная оспа. |

Если уровень эозинофилов ниже нормы
Эозинопения — это состояние, при котором уровень эозинофилов в крови снижается до менее чем 200 клеток на миллилитр.
Это явление может наблюдаться при различных заболеваниях и состояниях:
- Сепсис и тяжелые гнойные инфекции, когда организм не может производить достаточное количество эозинофилов.
- Воспалительные процессы в органах, такие как аппендицит, уролитиаз и панкреатит.
- Первые сутки после инфаркта миокарда.
- Шоковые состояния, включая болевой и инфекционный шок.
- Отравления тяжелыми металлами, такими как ртуть, мышьяк, медь, свинец, кадмий, висмут и таллий.
- Заболевания надпочечников и нарушения функции щитовидной железы.
- Хронический стресс.
При развитии лейкоза уровень эозинофилов может снижаться до нуля.
Комбинированные повышения эозинофилов
У людей с аллергическими реакциями при вирусных инфекциях наблюдается увеличение эозинофилов и лимфоцитов. Это состояние часто встречается у аллергиков с гельминтозами и дерматозами. Похожая картина может возникнуть у пациентов, проходящих лечение антибиотиками и сульфаниламидами. У детей рост эозинофилов и лимфоцитов может наблюдаться при инфекционном мононуклеозе и скарлатине. Поэтому важно провести дополнительные лабораторные исследования: анализ кала на наличие глистов, определение уровня иммуноглобулина Е и выявление антител к вирусу Эпштейна-Барра в крови.
Если на фоне повышенных эозинофилов наблюдается рост моноцитов, это может указывать на инфекционный процесс в организме. Чаще всего это связано с мононуклеозом. Аналогичная картина может возникнуть при саркоидозе, грибковых инфекциях, вирусных заболеваниях, туберкулезе, гонорее и риккетсиозе.
Записаться на приём к терапевту
Страница для записи к терапевту ➤
| Запись к другим специалистам: |
| Терапевт |
| Педиатр |
| Иммунолог |
| Аллерголог |
| Выбрать врача ➤ |
| Записаться на диагностику ➤ |
| Записаться на медицинскую услугу ➤ |
Вопрос-ответ
Как привести в норму эозинофилы?
Для нормализации уровня эозинофилов важно выявить и устранить причину их повышения, что может включать лечение аллергий, инфекций, аутоиммунных заболеваний или других состояний. Рекомендуется обратиться к врачу для диагностики и назначения соответствующей терапии, которая может включать антигистаминные препараты, кортикостероиды или другие медикаменты в зависимости от причины. Также полезно поддерживать здоровый образ жизни, включая сбалансированное питание и физическую активность.
Какой процент эозинофилов считается опасным?
Степени эозинофилии: слабая: концентрация эозинофилов увеличена на 10% относительно нормы; умеренная: уровень выше нормы на 10–15%; тяжёлая: содержание эозинофилов выше нормы на 15% и больше.
Какие таблетки снижают эозинофилы?
Алмонт снижает число эозинофилов в периферической крови у взрослых и детей, а также значительно снижает число эозинофилов в дыхательных путях.
Какой уровень эозинофилов указывает на наличие паразитов?
Один из признаков — уровень СОЭ выше 20 мм/час, но он может быть и нормальным. Для кишечных гельминтозов характерна анемия со снижением уровня гемоглобина менее 100 г/литр. Основной признак паразитарной инвазии — повышение уровня эозинофилов на 20%.
Советы
СОВЕТ №1
Проведите повторный анализ крови. Повышенные уровни эозинофилов могут быть временными и связаны с аллергическими реакциями или инфекциями. Повторный анализ поможет подтвердить или опровергнуть первоначальные результаты.
СОВЕТ №2
Обратитесь к врачу для определения причины повышения эозинофилов. Это может быть связано с аллергиями, паразитарными инфекциями или другими заболеваниями. Врач сможет назначить необходимые обследования и лечение.
СОВЕТ №3
Следите за своим состоянием и симптомами. Если вы замечаете такие симптомы, как зуд, сыпь, кашель или затрудненное дыхание, обязательно сообщите об этом врачу. Это поможет в диагностике и выборе правильного лечения.
СОВЕТ №4
Обратите внимание на свою диету и образ жизни. Употребление антиоксидантов, витаминов и минералов может помочь укрепить иммунную систему и снизить уровень воспаления в организме. Рассмотрите возможность консультации с диетологом.